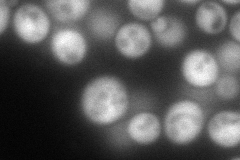
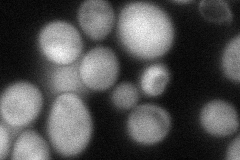

View description
HSP90 cofactor; interacts with Hsp82p, Pih1p, Rvb1 and Rvb2, contains a single TPR domain with at least two TPR motifs
Localization:
Intensity:
Fold change:
Significance:
-
C’ GFP library in SD

below threshold16.99 -
N' NOP1pr-GFP in SD
cytosol193.663 -
N' TEF2pr-mCherry in SD

punctate307.632 -
N' NATIVEpr-GFP in SD

nucleus44.7156 -
N' TEF2pr-VC and Cyto-VN in SD
cytosol71.6152 -
C’ GFP library in SD+DTT

cytosol16.80.98No -
C’ GFP library in SD+H2O2

cytosol19.391.14No -
C’ GFP library in Starvation Media

cytosol17.841.04No -
C’ GFP library on the background of Pup2-DaMP

below threshold -
C’ GFP library on the background of CCT mutant

below threshold14.97790.881164No
